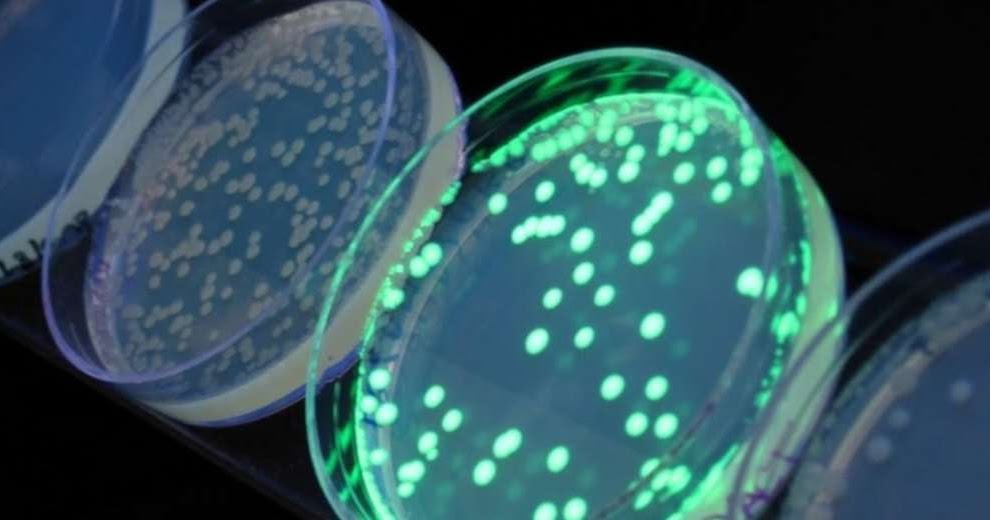

Se C3 B1al Luminosa V2

Para ello se determina el valor de 𝝎 por medio de la ecuación 15 1.
Se c3 b1al luminosa v2. A el voltaje de salida del detector de cuadratura b el voltaje de la señal en cuadratura o segunda señal de entrada al detector v2. Escuela politécnica del ejército repositorio de la universidad de. A es necesario obtener 𝒗𝒐𝒖𝒕 por ello se debe calcular los valores de 𝑮𝟏 y 𝜽. 2014 elaboración de una guía de trabajo para el desarrollo del laboratorio de la asignatura química i de la escuela de química de la universidad tecnológica.
Large ace unos meses atrás uno de mis amigos me pidió apoyo.